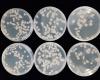

[충청권] 제천문화재단, 산책도서관과 함께하는 '독서의 달' 행사 |2025. 09.09 [충청권] 제천문화재단, 산책도서관과 함께하는 '독서의 달' 행사 |2025. 09.09
[HKS행정방송]제천문화재단은 9월 ‘독서의 달’을 맞이해 오는 10일부터 30일까지 산책도서관에서 다채로운 독서문화 프로그램을 운영한다.
산책도서관은 ‘여행’을 주제로 9월 독서의 달 행사를 꾸렸다. ‘5가지 스탬프 투어 미션’, ‘그림책 원화 전시’, ‘연체 지우개’를 행사 기간 상시 진행하며, 20일에는 '내 책을 당근해' 중고 도서… |
|
 [충청권] 제천문화재단, 윤희철 연극배우 변사극 운영 |2025. 09.09 [충청권] 제천문화재단, 윤희철 연극배우 변사극 운영 |2025. 09.09
[HKS행정방송]제천문화재단이 오는 13일 산책도서관에서'2025년 문학상주작가 지원사업'의 세 번째 프로그램으로 '희곡, 연극과 영상으로 맛보다'를 진행한다.
이번 프로그램은 희곡에 대한 이해를 높이고 흥미를 유발시키기 위해 진행되며, 연극과 영상으로 접목시킨 변사극을 연극배우인 윤희철 배우를 통해 선보일 예정이다.
윤희철 배우는… |
|
 [충청권] 한우·한돈·양봉협회, 영동군과 손잡고 ‘2025 영동세계국악엑스포’ 성공 개최 지원 |2025. 09.09 [충청권] 한우·한돈·양봉협회, 영동군과 손잡고 ‘2025 영동세계국악엑스포’ 성공 개최 지원 |2025. 09.09
[HKS행정방송]오는 9월 12일에 개막되는 2025 영동세계국악엑스포의 성공 개최를 위해 전국한우협회중앙회(회장 민경천), 대한한돈협회중앙회(회장 손세희) 및 한국양봉협회중앙회(회장 박근호)와 영동군이 손을 잡았다.
이번 엑스포 입장권 사전 구매는 축산 단체들과 영동군이 협력하여 영동세계국악엑스포의 성공적 개최를 뒷받침하고 문화와… |
|
 [충청권] 제천시 정신건강복지센터, 이호선 교수 초청 특별강연 개최 |2025. 09.09 [충청권] 제천시 정신건강복지센터, 이호선 교수 초청 특별강연 개최 |2025. 09.09
[HKS행정방송]제천시정신건강복지센터는 오는 10월 1일 오후 2시, 한방바이오엑스포공원 한방생명과학관 1층 다목적강당에서 ‘자살예방 및 정신건강의 날 기념 특별강연’을 개최한다.
이번 강연은 ‘자살예방의 날(9월 10일)’과 ‘정신건강의 날(10월 10일)’을 맞아, 시민들에게 정신건강의 중요성을 알리고 생명존중 문화를 확산하기 위해… |
|
 [충청권] 영동세계국악엑스포, 성공적인 개최를 위한 철저한 준비 |2025. 09.09 [충청권] 영동세계국악엑스포, 성공적인 개최를 위한 철저한 준비 |2025. 09.09
[HKS행정방송]영동세계국악엑스포조직위에서는 8일부터 9일 양일간 통합시운전을 통해 지난 5일 사전점검 시 제기된 문제점을 보완함은 물론, 구역별 이상 여부를 다시 한번 재점검한다고 밝혔다.
조직위는 엑스포 기간 중 발생할 수 있는 다양한 상황에 대응하기 위하여 실 개막 7일 전에 사전점검을 실시했고, 엑스포 행사장의 전반적인 준비… |
|
 [충청권] 영동군, 2025 영동세계국악엑스포와 힐링관광지 연계 체험 운영 ‘전통과 치유의 만남’ |2025. 09.09 [충청권] 영동군, 2025 영동세계국악엑스포와 힐링관광지 연계 체험 운영 ‘전통과 치유의 만남’ |2025. 09.09
[HKS행정방송]충북 영동군이 오는 9월 12일부터 10월 11일까지 열리는 ‘2025 영동세계국악엑스포’ 기간 동안 주요 힐링관광지에서 다양한 체험프로그램과 이벤트를 운영한다고 밝혔다.
이번 프로그램은 레인보우힐링센터, 힐링숲미디어관, 과일나라테마공원 등에서 진행되며, 관광객들의 만족도를 높이고 재방문을 유도해 지역 관광 활성화와… |
|
 [충청권] ‘국악의 향기, 세계를 물들이다’ 2025 영동세계국악엑스포 9월 12일 개막 공연·체험·전시·산업까지…국악의 미래를 여는 한 달 대장정 |2025. 09.09 [충청권] ‘국악의 향기, 세계를 물들이다’ 2025 영동세계국악엑스포 9월 12일 개막 공연·체험·전시·산업까지…국악의 미래를 여는 한 달 대장정 |2025. 09.09
[HKS행정방송]충북 영동군과 2025 영동세계국악엑스포 조직위원회는 “국악의 향기, 세계를 물들이다”라는 주제로 열리는 2025 영동세계국악엑스포가 오는 12일부터 10월 11일까지 레인보우힐링관광단지(주 행사장)와 심천면 국악체험촌(부 행사장, 영동난계국악축제 행사장) 일원에서 성대하게 펼쳐진다고 밝혔다.
이번 엑스포는 국악의 전통… |
|
 [충청권] 충남도 2026년 청년농업인 지원사업 대상자 공모 |2025. 09.09 [충청권] 충남도 2026년 청년농업인 지원사업 대상자 공모 |2025. 09.09
[HKS행정방송] 충남도 농업기술원은 ‘2026년 청년농업인 지원사업’ 공모를 진행 중이라고 9일 밝혔다.
이 사업은 지역 농업의 미래를 이끌 청년농업인을 발굴·육성하기 위한 것으로, 45억원을 투입한다.
지원 내용은 △영농 정착 기반조성(35곳, 1인당 5000만-1억원, 영농경력 3-11년 미만) △선도 청년농업인 성장 지원(10곳, 1억원,… |
|
 [충청권] 충남 자체 개발 ‘우수 토종 식품균주’ 기술이전 |2025. 09.09 [충청권] 충남 자체 개발 ‘우수 토종 식품균주’ 기술이전 |2025. 09.09
[HKS행정방송] 충남도 농업기술원은 우수 토종 식품균주 연구를 통해 자체 개발에 성공한 ‘토종 고초균(청국장균)’을 도내 가공업체에 기술이전(통상실시)한다고 9일 밝혔다.
이번에 개발한 토종 고초균(BC160CK48)은 모세혈관을 막아 뇌졸중 등 심각한 혈관질환을 유발하는 혈액 속 혈전을 녹이는 혈전용해 활성률이 87.9%를 기록했다.
… |
|
 [충청권] 충남도 보령 장고도, 자율관리어업 우수공동체 선정 |2025. 09.09 [충청권] 충남도 보령 장고도, 자율관리어업 우수공동체 선정 |2025. 09.09
[HKS행정방송] 충남도 수산자원연구소는 보령 장고도 자율관리어업공동체가 해양수산부 주관 올해 ‘자율관리어업공동체 평가’에서 우수공동체(장려)에 선정됐다고 9일 밝혔다.
자율관리어업공동체는 어업인 스스로 공동체를 결성하고 자체 규약을 수립해 수산자원 조성과 어장 환경 조성, 어업 질서 유지, 경영 개선 등을 통해 지속 가능한… |
|
 [충청권] 충남도 日 지상파 방송사와 충남관광 홍보 협력 |2025. 09.09 [충청권] 충남도 日 지상파 방송사와 충남관광 홍보 협력 |2025. 09.09
[HKS행정방송] 충남도는 ‘2025∼2026 충남 방문의 해’를 맞아 일본 지상파 방송사 BS후지 코리스트와 도내 주요 관광명소 홍보 기획방송을 제작한다고 9일 밝혔다.
이번 협력사업은 오는 10일부터 12일까지 3일간 진행되는 팸투어 촬영을 통해 추진되며, 본방송은 10월 5일 방영되고 일주일간 재방송된다.
방송에는 일본 현지 배우, 아… |
|
 [충청권] 제천시, 충북도 공립미술관 설립타당성 사전평가 통과 |2025. 09.09 [충청권] 제천시, 충북도 공립미술관 설립타당성 사전평가 통과 |2025. 09.09
[HKS행정방송]제천시가 추진 중인 제천시립미술관 건립 사업이 충청북도 공립미술관 설립타당성 사전평가를 통과하며 본격적인 추진에 속도를 내게 됐다.
충청북도는 지난 5일 공립미술관 설립타당성 사전평가 최종 심의에서 지역문화 발전성·설립 타당성·운영 지속 가능성 등 주요 항목을 긍정적으로 평가하며 최종 통과 결정을 내렸다.
제… |
|
 [충청권] 홍성군 갈산면, 백야 김좌진 장군 호국정신 계승 |2025. 09.09 [충청권] 홍성군 갈산면, 백야 김좌진 장군 호국정신 계승 |2025. 09.09
[HKS행정방송]홍성군 갈산면 주민자치회는 지난 3일, 주민자치 자체사업의 일환으로 가정용 국기 게양대를 설치하며 호국정신 계승과 쾌적한 농촌 환경 이미지를 제고하는 의미 있는 성과를 이뤘다고 밝혔다.
이번 국기게양대 설치사업은 갈산면 주민자치회에서 가가호호 설치하고 애국심과 공동체 의식을 높이는 한편 일제강점기 독립전쟁의 영… |
|
 [충청권] 홍성군드림스타트, 가족 힐링 캠프 성료 |2025. 09.09 [충청권] 홍성군드림스타트, 가족 힐링 캠프 성료 |2025. 09.09
[HKS행정방송]홍성군드림스타트는 지난 6일부터 7일까지 1박 2일간 드림스타트 대상 가족 39명과 함께‘가족 힐링 캠프’를 실시했다고 밝혔다.
이번 행사는 일상에서 벗어나 가족 간의 소통을 증진하고 유대감을 강화하기 위해 마련됐으며, 참가 가족들은 무주군 태권도원과 덕유산 리조트를 비롯해 가족 힐링 프로그램 반딧불 축제 등 다양… |
|
 [충청권] 홍성군 홍성읍, 생신 맞은 유공자 가정 찾아 |2025. 09.09 [충청권] 홍성군 홍성읍, 생신 맞은 유공자 가정 찾아 |2025. 09.09
[HKS행정방송]홍성군 홍성읍행정복지센터는 지난 5일, 6·25 참전유공자의 생신을 맞아 가정을 직접 방문해 군수 표창장을 전달하며 나라를 위한 헌신에 깊은 존경과 감사를 전했다.
이번 표창 수여는 나라를 지키기 위해 희생하신 참전유공자에 대한 예우와 감사의 뜻을 전하고자 마련된 자리로, 유철식 홍성읍장을 비롯한 직원들이 함께 참석… |
|
 [충청권] 제천문화재단, 산책도서관과 함께하는 '독서의 달' 행사 |2025. 09.09
[충청권] 제천문화재단, 산책도서관과 함께하는 '독서의 달' 행사 |2025. 09.09
 [충청권] 제천문화재단, 윤희철 연극배우 변사극 운영 |2025. 09.09
[충청권] 제천문화재단, 윤희철 연극배우 변사극 운영 |2025. 09.09
 [충청권] 한우·한돈·양봉협회, 영동군과 손잡고 ‘2025 영동세계국악엑스포’ 성공 개최 지원 |2025. 09.09
[충청권] 한우·한돈·양봉협회, 영동군과 손잡고 ‘2025 영동세계국악엑스포’ 성공 개최 지원 |2025. 09.09
 [충청권] 제천시 정신건강복지센터, 이호선 교수 초청 특별강연 개최 |2025. 09.09
[충청권] 제천시 정신건강복지센터, 이호선 교수 초청 특별강연 개최 |2025. 09.09
 [충청권] 영동세계국악엑스포, 성공적인 개최를 위한 철저한 준비 |2025. 09.09
[충청권] 영동세계국악엑스포, 성공적인 개최를 위한 철저한 준비 |2025. 09.09
 [충청권] 영동군, 2025 영동세계국악엑스포와 힐링관광지 연계 체험 운영 ‘전통과 치유의 만남’ |2025. 09.09
[충청권] 영동군, 2025 영동세계국악엑스포와 힐링관광지 연계 체험 운영 ‘전통과 치유의 만남’ |2025. 09.09
 [충청권] ‘국악의 향기, 세계를 물들이다’ 2025 영동세계국악엑스포 9월 12일 개막 공연·체험·전시·산업까지…국악의 미래를 여는 한 달 대장정 |2025. 09.09
[충청권] ‘국악의 향기, 세계를 물들이다’ 2025 영동세계국악엑스포 9월 12일 개막 공연·체험·전시·산업까지…국악의 미래를 여는 한 달 대장정 |2025. 09.09
 [충청권] 충남도 2026년 청년농업인 지원사업 대상자 공모 |2025. 09.09
[충청권] 충남도 2026년 청년농업인 지원사업 대상자 공모 |2025. 09.09
[충청권] 충남 자체 개발 ‘우수 토종 식품균주’ 기술이전 |2025. 09.09
[충청권] 충남 자체 개발 ‘우수 토종 식품균주’ 기술이전 |2025. 09.09
 [충청권] 충남도 보령 장고도, 자율관리어업 우수공동체 선정 |2025. 09.09
[충청권] 충남도 보령 장고도, 자율관리어업 우수공동체 선정 |2025. 09.09
 [충청권] 충남도 日 지상파 방송사와 충남관광 홍보 협력 |2025. 09.09
[충청권] 충남도 日 지상파 방송사와 충남관광 홍보 협력 |2025. 09.09
 [충청권] 제천시, 충북도 공립미술관 설립타당성 사전평가 통과 |2025. 09.09
[충청권] 제천시, 충북도 공립미술관 설립타당성 사전평가 통과 |2025. 09.09
 [충청권] 홍성군 갈산면, 백야 김좌진 장군 호국정신 계승 |2025. 09.09
[충청권] 홍성군 갈산면, 백야 김좌진 장군 호국정신 계승 |2025. 09.09
 [충청권] 홍성군드림스타트, 가족 힐링 캠프 성료 |2025. 09.09
[충청권] 홍성군드림스타트, 가족 힐링 캠프 성료 |2025. 09.09
 [충청권] 홍성군 홍성읍, 생신 맞은 유공자 가정 찾아 |2025. 09.09
[충청권] 홍성군 홍성읍, 생신 맞은 유공자 가정 찾아 |2025. 09.09
 2026.01.09(금) 18:54
2026.01.09(금) 18:54












